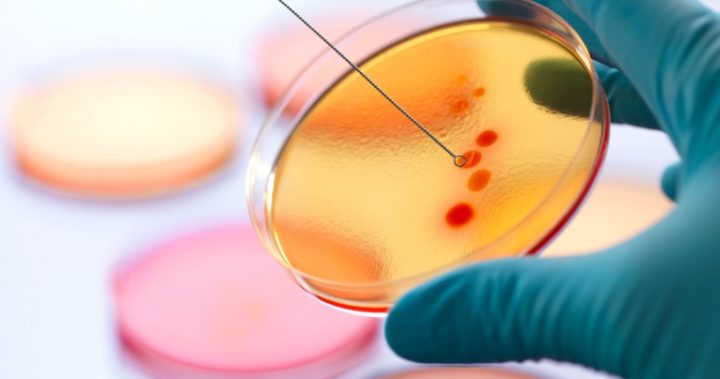

If you thought last year’s flu season was bad, it’s nothing compared to what billionaire and founder of Microsoft Bill Gates is predicting.
Speaking at an event hosted by the Massachusetts Medical Society and the New England Journal of Medicine, the 62-year-old said the world wasn’t prepared for a new pandemic of influenza that has the potential to kill millions. He told the crowd he was usually optimistic, but enough emphasis isn’t being put on protecting the population against new disease threats. He said there is “a significant probability of a large and lethal modern-day pandemic occurring in our lifetimes,” according to Gizmodo.
As many as 33 million people could be killed within six months if bacteria and diseases continue to evolve and develop. With the world more connected than ever before, it would take one infected person hoping on a plane and travelling overseas for things to get quickly out of hand. He compared the possibility of a new outbreak to the 1918 Influenza Pandemic.
Although that pandemic occurred 100 years ago, 50 million people are believed to have died, with 500 million people around the world becoming infected. As much as five per cent of the world’s population were lost to that outbreak. Many could meet a similar end if governments don’t take the possibility of new threats seriously.
Gates has released a simulation of how the disease could quickly take over the world. Originating in Asia, more than 28,000 lives would be lost within the first month alone, before it continues rapidly across all continents.
It’s not the first time the world has been warned of dangerous new disease. Last month, the World Health Organization (WHO) warned that an array of new diseases may soon have the potential to kill millions of people around the world.
WHO said it developed a tool to determine which diseases and pathogens pose a public health risk because of their epidemic potential. It also highlighted diseases where there are currently no cures of effective preventative measures. Of the nine diseases that made the list, the most worrying is simply known as “Disease X”. It is believed that Disease X has the potential to mutate from existing diseases such as HIV or the Spanish Flu, although it isn’t yet a disease in its own right.
“Disease X represents the knowledge that a serious international epidemic could be caused by a pathogen currently unknown to cause human disease, and so the R&D Blueprint explicitly seeks to enable cross-cutting R&D preparedness that is also relevant for an unknown ‘Disease X’ as far as possible,” WHO said of Disease X in the 2018 annual review of the Blueprint list of priority diseases.
Other diseases WHO is particularly concerned about include Zika, Rift Valley fever, Ebola and Lassa fever. It comes as more common diseases and infections are resisting treatment that usually work. In the UK, a man endured months of suffering after contracting an intense version of gonorrhoea. While health professionals have managed to treat the sexually transmitted infection now, they have warned other infections are mutating and resisting treatment that are meant to work.
Similarly in Australia, a flesh-eating bacteria is causing gruesome ulcers across the state of Victoria. Numbers have increased by 51 per cent in a single year, although health professionals are currently baffled as to how humans contracted the bacteria.